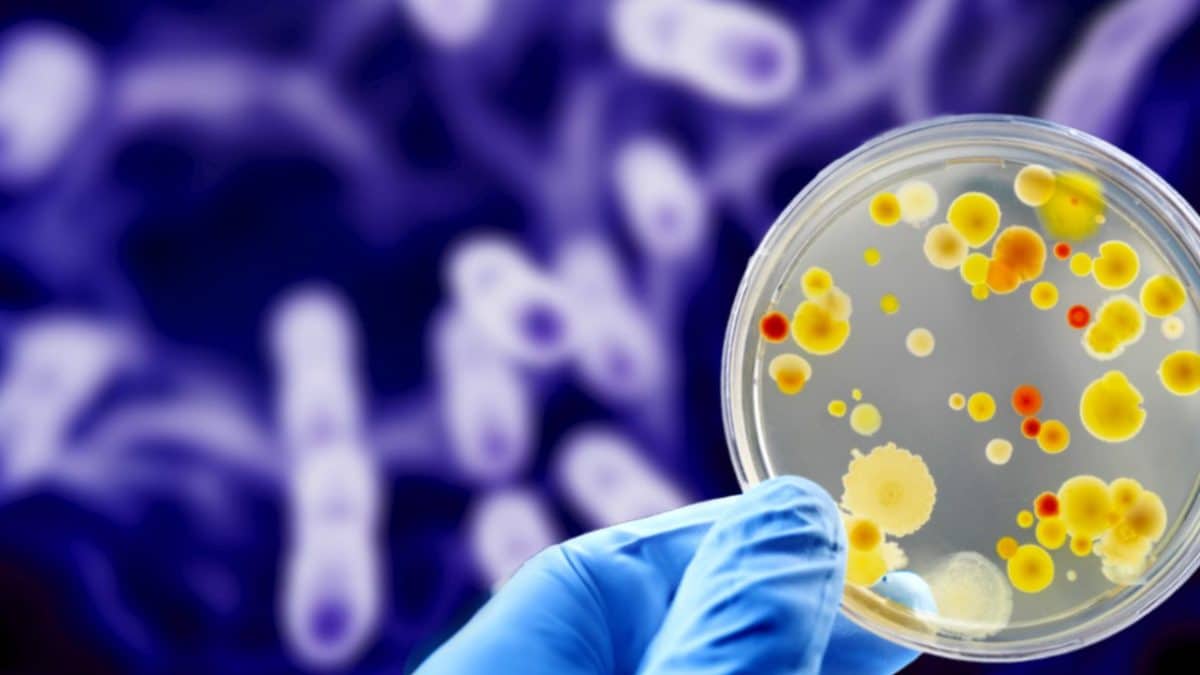
Antibiotico-resistenza cos'è

Virus e batteri sono onnipresenti nella nostra vita. Non solo per le malattie infettive: si stima per esempio che siano 100.000 miliardi i batteri che vivono nel nostro organismo, aiutandoci a svolgere una grande quantità di funzioni. Sono microrganismi estremamente importanti per noi, nel bene e nel male, eppure spesso ci capita di confonderli o di considerarli all'interno di un'unica categoria. Si tratta invece di organismi molto differenti tra loro: vediamo quindi le differenze tra gli uni e gli altri
Le differenze tra virus e batteri
La differenza più importante è che i virus non sono universalmente considerati viventi, mentre non c'è dubbio che i batteri siano forme di vita. Nello specifico, i batteri sono procarioti, organismi unicellulari semplici composti da una sola cellula priva di nucleo ben definito dal resto della cellula.

Di conseguenza, i virus non hanno tutte quelle caratteristiche che accomunano tutti gli esseri viventi. In particolare, non possono riprodursi autonomamente: per farlo necessita di un organismo ospite, senza il quale non può sopravvivere a lungo. I batteri invece si riproducono senza la necessità di un altro essere vivente (lo fanno in modo asessuato, per scissione binaria) e possono sopravvivere relativamente a lungo fuori da un organismo ospite.
Inoltre, i virus non possiedono organelli interni in grado di svolgere compiti specifici, come invece avviene per tutte le cellule viventi. Sono composti essenzialmente da un capside proteico e dal materiale genetico (RNA o DNA) contenuto al suo interno, che contiene le informazioni per realizzare il capside.

Virus e batteri sono “buoni” o “cattivi”?
Di tutti i batteri conosciuti, solo l’1% è effettivamente pericoloso per l’uomo. La maggioranza dei batteri che convivono pacificamente con l’uomo si trova nel tratto urinario, gastrointestinale, nella cavità orale e sulla pelle. Questi eubatteri vengono detti residenti e fanno parte del microbiota, cioè l'insieme di tutti i microrganismi che convivono nel nostro organismo senza arrecare danno a quest'ultimo. Quella comunemente nota come flora intestinale, per esempio, è proprio il nostro microbiota nel nostro intestino, indispensabile per i processi di digestione e per difesa da altri agenti patogeni.
I batteri che hanno conseguenze negative per l’uomo sono quelli che producono tossine (come quella botulinica o tetanica) o quelli che penetrano accidentalmente dove non dovrebbero, pur essendo parte della flora residente.
I virus patogeni per l'uomo sono circa 200 specie. Nel 2022, le specie di virus ufficialmente riconosciute dall'ICTV (International Committee on Taxonomy of Viruses) erano circa 10.000. Questo significa una percentuale del 2%. Più o meno, virus e batteri patogeni si equivalgono in termini percentuali.